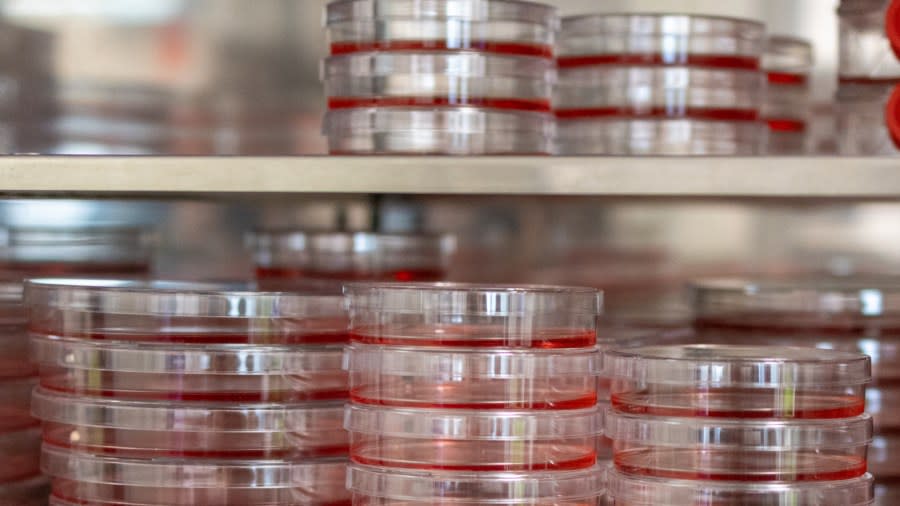

GRAND RAPIDS, Mich. (WOOD) — A team of researchers from Henry Ford Health and Michigan State University’s Health Sciences have found a mechanism that allows certain forms of cancers to evade immune systems. They also figured out how to disable it.
Dohun Pyeon, a professor in MSU’s Department of Microbiology, Genetics & Immunology, led the study. It was published last month in the academic journal Proceedings of the National Academy of Sciences.
Experts have known for years that several cancers associated with HPV, the human papillomavirus, do not have MHC-1 molecules, which signal distress to the body.
“Without these molecular red flags, the immune system simply doesn’t see that there is a problem with the cell,” the university wrote in a blog post. “Until now, the field had only fragments of the explanation.”
Pyeon says their study demonstrates how HPV co-opts a protein called MARCHF8 to dismantle the cell’s markers before the immune system can recognize cancerous cells. He says the cancers work similar to how the herpes virus operates.
“For a virus to survive in a host cell, that is the first target to eliminate. (It makes) them invisible inside the cells,” Pyeon told News 8. “But HPV is too small compared to the herpes virus. They don’t have a capacity to have their own protein.

Dohun Pyeon is a professor in Michigan State University’s Department of Microbiology, Genetics & Immunology. (Courtesy MSU College of Human Medicine)
“But other people found that MARCHF8 is very similar to this herpes virus molecule. … So, we started investigating this molecule and (found) HPV doing exactly the same functions to eliminate this MHC-1 molecule using the host protein,” he continued.
Pyeon’s team experimented with cancer cells that had the MARCHF8 protein removed and found that the immune response was much more effective, even in cases in which previous immunotherapy had failed.
MSU study shows PFAS weakens immune systems
“(It made them) visible to killer T-cells, to eliminate the cancer cells. That’s really exciting,” Pyeon said.
Pyeon said his team has several questions to tackle next. They plan to dig deeper to learn more about MARCHF8. They want to develop inhibitors that can work with current immunotherapies to remove MARCHF8 and they want to learn more about how different immune cells work with T-cells in killing cancerous cells once the MHC-1 markers are restored.
Copyright 2026 Nexstar Media, Inc. All rights reserved. This material may not be published, broadcast, rewritten, or redistributed.
For the latest news, weather, sports, and streaming video, head to WOODTV.com.

